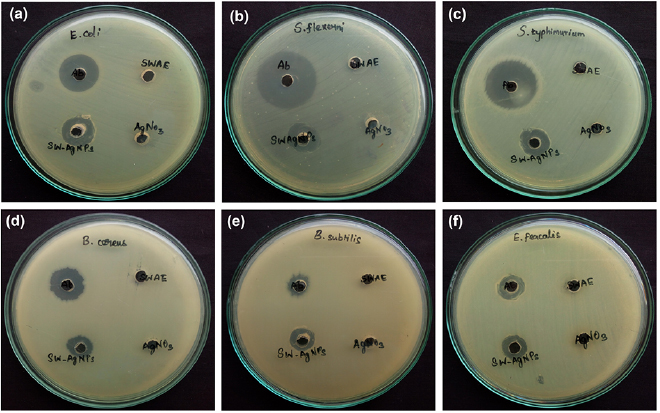
Figure 10.

Abstract
Diabetes mellitus is a common metabolic disorder characterized by hyperglycemia and is a major cause of blindness, kidney failure, heart attack, stroke and is also responsible for lower limb amputation. The purpose of the present study was to evaluate the antioxidant and enzyme inhibitory efficacy of silver nanoparticles synthesized from brown alga, Sargassum wightii. The synthesized silver nanoparticles revealed spherical morphology with the size range of 18.45–41.59 nm. The green synthesized sliver nanoparticles of S. wightii were characterized through UV-visible spectroscopy, Fourier transform infrared spectroscopy, x-ray diffraction, field emission scanning electron microscopy, energy dispersive x-ray spectroscopy, zeta potential and by dynamic light scattering method. Presently, the enzyme inhibitory property  of S. wightii-aqueous extract and synthesized silver nanoparticles of S. wightii against
of S. wightii-aqueous extract and synthesized silver nanoparticles of S. wightii against  amylase and
amylase and  glucosidase was found to be 252.8 and
glucosidase was found to be 252.8 and  , and 284.18 and
, and 284.18 and  , respectively. Similar trend of antioxidant activity have been recorded. The presently synthesized silver nanoparticle through green approach is an eco-friendly and cost effective one and it could form an effective pharmacological agent.
, respectively. Similar trend of antioxidant activity have been recorded. The presently synthesized silver nanoparticle through green approach is an eco-friendly and cost effective one and it could form an effective pharmacological agent.
Export citation and abstract BibTeX RIS

Original content from this work may be used under the terms of the Creative Commons Attribution 3.0 licence. Any further distribution of this work must maintain attribution to the author(s) and the title of the work, journal citation and DOI.
1. Introduction
Diabetes mellitus (DM) is a chronic metabolic disorder which occurs due to insufficient or ineffective insulin production. Hyperglycaemia is an increased blood sugar level of DM and its prolonged condition results in serious damage to the nerves and blood vessels [1]. According to the WHO (2017), 8.5% of 18-year olds were found to be diabetics. And this extended disease condition had caused 2.2 million deaths in 2012 and 1.6 million in 2015. Globally, 8% or 205 million women are living with DM and half of them belong to south-east Asia and the western Pacific. The increased blood sugar level during the pregnancy period creates the health risk to both mother and child and which also transmits diabetes to the child in near future. Type 2 diabetes mellitus is characterized by hyperglycemia and insulin resistance in more than 90% of patients. Type 2 diabetic patients often develop dyslipidemia and other metabolic abnormalities along with insulin resistance and subsequent complications like atherosclerosis. Hence DM is one of the primary threats to human health due to its increased prevalence, chronic course and disabling complications [2]. The treatments for type 2 DM are doing regular physical exercise, proper intake of diet besides oral drug medications. The currently available therapies for type 2 DM are biguanides and thiazolidinedione that are losing their effectiveness against this disease by showing drug resistance resulting in serious side effects, like heart failure or liver disease, cardiovascular risk, hepatotoxicity, hypoglycemia, weight gain, lactic acidosis, acute pancreatitis and gastrointestinal adverse effects. Hence the necessity for safe antidiabetic medicines from natural plant sources seems to be promising [3]. Therefore, the search for more effective and safer eco-based nano formulation of hypoglycemic agents has continued to be an important area of investigation.
Nanoparticles are being considered to be the base of the nanotechnology. The most important and distinct property of nanoparticles is that they exhibit larger surface to volume ratio. For the synthesis of nanoparticles, the chemical and biological methods have been widely followed. Among these, the biological synthesis method has been generally followed by various researchers due to its single step process, low-cost production, eco-friendly approach and this method can be effectively used for large scale production. And also this method does not require any toxic chemicals, high pressure, temperature and energy that may show side effects in clinical studies [4]. The bioactive metabolites present in the seaweed extracts like flavonoids, phenols, citric acid, ascorbic acid, polyphenolic, terpenes, alkaloids and reductase could act as reducing agents [5]. The earlier studies reported that the seaweeds, Turbinaria conoides [6], Galaxaura elongata [7], Sargassum ilicifolium [8], Padina tetrastromatica [9], Corallina officinalis [10], Padina boergesenii [10], Sargassum muticum [11], Sargassum glaucescens [12], Sargassum polycystum [13], Turbinaria ornata [14, 15], Enteromorpha compressa [16] and Cystoseira baccata [17] are excellent source for the synthesis of nanoparticles that show the potential of antibacterial, anticancer and mosquito-larvicidal property. Sargassum wightii Greville ex J Agardh 1848 is a brown alga belonging to the family, Sargassaceae and order Fucales and is widely distributed in both tropical and temperate coastal regions. A wide range of biological properties of this seaweed have been reported which includes antibacterial [18], antidiabetic [19], antioxidant [20], anti-inflammatory and antihypertensive properties [21]. In view of the above, the present study was focused on enzyme inhibitory, antibacterial and antioxidant efficacy of seaweed, Sargassum wightii mediated silver nanoparticles.
2. Materials and methods
2.1. Seaweed collection and processing
Fresh marine algal samples were collected from the intertidal region of Mandapam, Tamil Nadu, Southeast coast of India  (figure 1). The collected seaweed samples were immediately thoroughly washed with marine water to remove the unwanted solid particles and then transported to laboratory in a plastic cover. Samples were washed thoroughly with tap water followed by distilled water until the debris and associated biota were removed and then dried for 3 weeks at room temperature under shade condition. The dried materials of all the seaweed were ground using the kitchen electric blender. The alga was identified based on the morphological features by referring standard keys [22] and the identification was then confirmed by Dr N. Kaliaperumal, Central Marine Fisheries Research Institute (CMFRI), Mandapam Camp, Ramanathapuram District, India. The reference specimens (PU/MBEG/V.022) have been kept in the Marine Biology and Ecological Genetics Laboratory for further reference. Chemicals used in this study were of maximum purity with analytical grade, purchased from Hi-Media Pvt. Ltd (India).
(figure 1). The collected seaweed samples were immediately thoroughly washed with marine water to remove the unwanted solid particles and then transported to laboratory in a plastic cover. Samples were washed thoroughly with tap water followed by distilled water until the debris and associated biota were removed and then dried for 3 weeks at room temperature under shade condition. The dried materials of all the seaweed were ground using the kitchen electric blender. The alga was identified based on the morphological features by referring standard keys [22] and the identification was then confirmed by Dr N. Kaliaperumal, Central Marine Fisheries Research Institute (CMFRI), Mandapam Camp, Ramanathapuram District, India. The reference specimens (PU/MBEG/V.022) have been kept in the Marine Biology and Ecological Genetics Laboratory for further reference. Chemicals used in this study were of maximum purity with analytical grade, purchased from Hi-Media Pvt. Ltd (India).
Figure 1. Brown alga, Sargassum wightii.
Download figure:
Standard image High-resolution image2.2. Preparation of aqueous seaweed extracts (SW-AE)
Seaweed aqueous extract was prepared by dissolving 10 g of seaweed powder with 100 ml of sterile double distilled water and constantly stirred with glass rod under 60 °C for 30 min. Then the resultant mixture was filtered through Whatman no. 1 filter paper and 100 ml of the filtrate was lyophilized using Mini Lyodel (Delvac, India) to remove the water content and stored at refrigerator for further assays.
2.3. Phytochemical analysis
The preliminary phytochemical analysis of SW-AE was performed as per the standard protocol [23]. In brief, 50 mg SW-AE was dissolved with 5 ml of sterile distilled water and used for the following analyses. For flavonoids few drops of 1% ammonia solution added to the 5 ml of SW-AE in a test tube. The formation of yellow color would indicate the presence of flavonoid compounds. For saponin, 50 mg of SW-AE was diluted using distilled water and made up to 20 ml. The suspension was shaken in a graduated cylinder for 15 min at room temperature. The formation of 2 cm layer of foam would indicate the presence of saponin. For tannins, about 0.5 mg of SW-AE was boiled in 20 ml of distilled water in a test tube and then filtered. The ferric chloride solution (0.1%) was added to the filtrate sample and the appearance of green color would indicate the presence of tannins. For alkaloids, 50 mg of SW-AE was stirred with a 5 ml of diluted HCl and filtered. To a 5 ml of filtrate, two drops of Mayer's reagents were added in the sides of the test tube (Mayer's reagent preparation: 1.358 g of mercuric chloride was dissolved in 60 ml of water, and 5.0 g of potassium iodide was dissolved in 10 ml of water. The two solutions were mixed and made up to 100 ml with water). A white color precipitate appearance would indicate the test as positive.
For phenolic compounds, SW-AE (50 mg) was dissolved in 5 ml of distilled water. To this, a few drops of neutral 5% ferric chloride solution was added. The development of dark green color would indicate the presence of phenolic compounds. For steroids, SW-AE (50 mg) was dissolved in 10 ml of chloroform and equal volume of concentration of  was added in the sides of the test tube. The change of upper layer to red and sulfuric acid layer to yellow with green fluorescence would indicate the presence of steroids.
was added in the sides of the test tube. The change of upper layer to red and sulfuric acid layer to yellow with green fluorescence would indicate the presence of steroids.
2.4. Synthesis of Sargassum wightii-silver nanoparticles (SW-AgNPs)
88 ml of 1 mM  (16.96 mg in 100 ml milli-Q water) was treated with 12 ml of SW-AE solution in an Erlenmeyer flask and incubated at room temperature for overnight (24 h) to observe the color change from brownish yellow to brown solution would indicate the formation of AgNPs [14].
(16.96 mg in 100 ml milli-Q water) was treated with 12 ml of SW-AE solution in an Erlenmeyer flask and incubated at room temperature for overnight (24 h) to observe the color change from brownish yellow to brown solution would indicate the formation of AgNPs [14].
2.5. Characterization of SW-AgNPs
The reduction of silver nitrate in the aqueous extract of S. wightii was recorded using UV-visible spectrophotometer (Cyber Lab UV-100) between 300 to 800 nm. The purification of synthesized silver nanoparticles was performed with repeated centrifugation of silver nanoparticles solution at 10,000 rpm for 10 min and the resultant pellet was suspended in double distilled water, air dried and estimated using electronic weighing balance (Shimadzu, BL-220h, Japan). The centrifuged and parched material containing silver nanoparticles was used for x-ray diffraction (XRD) studies, operated at a voltage of 40 kV and a current of 30 mA and the scanning was done at the range of 20°–90° (Advance power x-ray diffractometer, Brucker, Germany model D8).
The FTIR analyses of SW-AE and SW-AgNPs were observed in the mid-IR region 4000–400 cm−1 at a resolution of 4 cm−1 (Perkin-Elmer spectrum 2000). In both the analyses 1 mg of each sample was assorted with hundred milligram of potassium bromide (KBr) and then condensed to prepare salt-disc. The presence of silver ions, size and morphology of the SW-AgNPs were analysed by using 10 kV field emission-scanning electron microscope coupled with energy dispersive x-ray spectroscopy (EDX) (FE-SEM; JEOL, model JFC-1600). The zeta potential measurement and particle size analysis of SW-AgNPs was performed by particle size analyzer system (Zeta-sizer, Malvern Instruments Ltd, USA).
2.6.  amylase inhibitory activity
amylase inhibitory activity
The  amylase inhibitory activity of samples and acarbose was evaluated according to the procedure of Matsui et al [24]. The reactant mixture contains two hundred micro liter of starch
amylase inhibitory activity of samples and acarbose was evaluated according to the procedure of Matsui et al [24]. The reactant mixture contains two hundred micro liter of starch  and
and  of SW-AE, SW-AgNPs and acarbose
of SW-AE, SW-AgNPs and acarbose  at varied concentration
at varied concentration  were dissolved in phosphate buffer (20 mM
were dissolved in phosphate buffer (20 mM  and 6.7 mM NaCl, pH 6.9). Consequently, fifty micro liter of
and 6.7 mM NaCl, pH 6.9). Consequently, fifty micro liter of  amylase solution prepared with phosphate buffer was added to the reactant mixture and the final volume was made up to
amylase solution prepared with phosphate buffer was added to the reactant mixture and the final volume was made up to  with phosphate buffer solution. Then, the enzymatic reaction was allowed for 3 min at dark incubation condition at room temperature. After the incubation 1 ml of 0.1% hydrochloric acid was added to terminate the reaction. Subsequently, few drops of iodine reagent were mixed to the reactant mixture. The
with phosphate buffer solution. Then, the enzymatic reaction was allowed for 3 min at dark incubation condition at room temperature. After the incubation 1 ml of 0.1% hydrochloric acid was added to terminate the reaction. Subsequently, few drops of iodine reagent were mixed to the reactant mixture. The  amylase inhibitory activity was measured at 660 nm using a multi-well ELISA plate reader (Tokyo, Japan).
amylase inhibitory activity was measured at 660 nm using a multi-well ELISA plate reader (Tokyo, Japan).
2.7. α- glucosidase inhibitory activity
The  glucosidase inhibitory activity of samples and acarbose was performed according to the modified method of Sheliya et al [25]. In brief,
glucosidase inhibitory activity of samples and acarbose was performed according to the modified method of Sheliya et al [25]. In brief,  of SW-AE, SW-AgNPs and acarbose
of SW-AE, SW-AgNPs and acarbose  at different concentrations
at different concentrations  and
and  of 0.1 M phosphate buffer (pH 6.8) containing α-glucosidase solution
of 0.1 M phosphate buffer (pH 6.8) containing α-glucosidase solution  were incubated at 37 °C for 10 min. After,
were incubated at 37 °C for 10 min. After,  of 2.5 mM p-nitrophenyl-
of 2.5 mM p-nitrophenyl- D-glucopyranoside (PNPG) solution was added in the same buffer and incubated for 20 min. Then, the reaction was terminated by adding
D-glucopyranoside (PNPG) solution was added in the same buffer and incubated for 20 min. Then, the reaction was terminated by adding  of 0.2 M Na2CO3 and absorbance was recorded at 405 nm.
of 0.2 M Na2CO3 and absorbance was recorded at 405 nm.
2.8. DPPH radical scavenging assay
DPPH (1,1-diphenyl-2-picryl-hydrazyl) radical scavenging activity of samples and ascorbic acid were performed according to the standard method [26]. In brief, 2 ml of SW-AE, SW-AgNPs and ascorbic acid  at different concentrations (3.125, 6.25, 12.50, 25, 50 and
at different concentrations (3.125, 6.25, 12.50, 25, 50 and  ) were incorporated with 1 ml of 0.1 mM DPPH solution. Then the reaction mixture was immediately shaken for a few seconds and incubated at dark condition for 30 min. The OD values of the samples and control were recorded at 517 nm.
) were incorporated with 1 ml of 0.1 mM DPPH solution. Then the reaction mixture was immediately shaken for a few seconds and incubated at dark condition for 30 min. The OD values of the samples and control were recorded at 517 nm.
2.9. Ferric ion reducing power (FRAP) assay
FRAP scavenging property of SW-AE and SW-AgNPs was evaluated according to the protocol of Adedayo et al [27] with slight modification. The preparation of FRAP stock solution  ferric chloride hexahydrate,
ferric chloride hexahydrate,  TPTZ (2, 4, 6- tri [2-pyridyl]-s-triazine) and
TPTZ (2, 4, 6- tri [2-pyridyl]-s-triazine) and  acetate buffer (pH 3.6) solution. The working solution of FRAP reagent was equipped by mixing 4 ml of ferric chloride hexahydrate solution, 30 ml of acetate buffer and 4 ml of TPTZ solution. Five hundred micro liters
acetate buffer (pH 3.6) solution. The working solution of FRAP reagent was equipped by mixing 4 ml of ferric chloride hexahydrate solution, 30 ml of acetate buffer and 4 ml of TPTZ solution. Five hundred micro liters  of different concentrations of SW-AE, SW-AgNPs and ascorbic acid
of different concentrations of SW-AE, SW-AgNPs and ascorbic acid  were added to the test tubes containing 2.5 ml of FRAP solution and incubated at dark condition for 30 min. The OD value of the sample and ascorbic acid was recorded at 593 nm. Three replications were performed for the tested assay and statistical analysis was performed.
were added to the test tubes containing 2.5 ml of FRAP solution and incubated at dark condition for 30 min. The OD value of the sample and ascorbic acid was recorded at 593 nm. Three replications were performed for the tested assay and statistical analysis was performed.
The in vitro antioxidant and diabetic enzyme inhibitory activities of the samples were calculated using the following formula:

where  is absorbance of the control,
is absorbance of the control,  is absorbance of the sample.
is absorbance of the sample.
The inhibitory activity of samples and standards were expressed by the inhibitory concentration  values that were calculated using Graph pad prism version 5 (California, USA).
values that were calculated using Graph pad prism version 5 (California, USA).
2.10. Antibacterial activity
The antibacterial activities of the SW-AE and SW-AgNPs were evaluated by the agar well diffusion method [28]. Nutrient agar plates containing 15 ml of solidified medium were inoculated with  of overnight bacterial culture of Escherichia coli, Pseudomonas aeruginosa, Salmonella typhimurium, Shigella flexneri, Bacillus subtilis, Bacillus cereus and Enterococcus faecalis. Then the plates were punched to make wells of 7 mm with diameter of 7 mm in the agar and filled with samples (SWAE and SW-AgNPs) and standard. The plates were incubated for 24 h at 37 °C. After the period of incubation the plates were examined for the bacterial lawn and the diameters of the inhibition zones were measured.
of overnight bacterial culture of Escherichia coli, Pseudomonas aeruginosa, Salmonella typhimurium, Shigella flexneri, Bacillus subtilis, Bacillus cereus and Enterococcus faecalis. Then the plates were punched to make wells of 7 mm with diameter of 7 mm in the agar and filled with samples (SWAE and SW-AgNPs) and standard. The plates were incubated for 24 h at 37 °C. After the period of incubation the plates were examined for the bacterial lawn and the diameters of the inhibition zones were measured.
3. Results and discussion
3.1. Phytochemical analysis
The preliminary phytochemical analysis of SW-AE revealed the presence of flavonoids, alkaloids, phenolics and steroids. Saponins and tannins were found to be absent (table 1). Some earlier studies have revealed that seaweed is an excellent source for bioactive molecules like sterols, carotenoids, fatty acid, pigments, tannins, bromophenols, flavonoids, polysaccharides, and phenolic acids that were researched for different biological properties [29]. The seaweed-phyco-constituents such as phenols and flavonoids were earlier found to have inhibition capacity of free radicals like those of our present findings [30].
Table 1. Phytochemical screening of SW-AE.
| Phytochemical | SW-AE |
|---|---|
| Flavonoids | + |
| Saponins | − |
| Tannins | − |
| Alkaloids | + |
| Phenolics | + |
| Steroids | + |
[+] present. [−] absent.
3.2. Synthesis of SW-AgNPs
The bioreduction of silver nitrate into silver by the action of seaweed extract was observed visually through the color changes in SW-AE from pale brown color to blackish brown color (figure 2). Such blackish-brown color formation of the synthesized silver nanoparticles could be due to the ion excitation from silver nitrate to silver which was recorded at 420 nm, indicating the formation of silver nanoparticles. The purification process of synthesized silver nanoparticles solution (100 ml) through centrifugation process yielded 10 mg of SW-AgNPs. The uses of seaweeds for the synthesis of nanoparticles are advantageous over chemical and bacterial culture mediated synthesis, as the method eliminates tedious steps, use of toxic chemicals and frequent change of culture conditions. Moreover, the fabrication of nanoparticles using seaweed extract is cost effective and eco-friendly one with single step process [31]. The formation of silver nanoparticles upon the reduction of  ions had occurred by adding the seaweed extract with a strong surface plasmon resonance recorded at 420 nm (figure 3).
ions had occurred by adding the seaweed extract with a strong surface plasmon resonance recorded at 420 nm (figure 3).
Figure 2. Synthesis of silver nanoparticles using S. wightii: (a) SW-AE, (b)  and (c) SW-AgNPs.
and (c) SW-AgNPs.
Download figure:
Standard image High-resolution imageFigure 3. UV-vis absorption spectra of SW-AE and SW-AgNPs.
Download figure:
Standard image High-resolution image3.3. Characterization of SW-AgNPs
The XRD pattern of SW-AgNPs showed the  values of
values of  ,
,  ,
,  and
and  corresponding to (101), (111), (110) and (422), respectively (figure 4). A few unassigned peaks were also noticed in the vicinity of the characteristic peaks. Such peaks occurrence might have been due to the signals received from capping agents present in the aqueous solution of seaweed [32]. The biological activity of any bio-organic compound could be influenced by its functional groups. Hence, the FTIR analysis of the seaweed aqueous extract and synthesized nanoparticles would shed light on the physicochemical properties of a compound [33]. The FTIR analysis of SW-AE (figure 5(a)) revealed the peak vibrations at 3448.68, 2920.32, 2852.88, 2360.77, 1636.59, 1463.69, 1383.79, 1109.73 and
corresponding to (101), (111), (110) and (422), respectively (figure 4). A few unassigned peaks were also noticed in the vicinity of the characteristic peaks. Such peaks occurrence might have been due to the signals received from capping agents present in the aqueous solution of seaweed [32]. The biological activity of any bio-organic compound could be influenced by its functional groups. Hence, the FTIR analysis of the seaweed aqueous extract and synthesized nanoparticles would shed light on the physicochemical properties of a compound [33]. The FTIR analysis of SW-AE (figure 5(a)) revealed the peak vibrations at 3448.68, 2920.32, 2852.88, 2360.77, 1636.59, 1463.69, 1383.79, 1109.73 and  . The peaks at 3448.68, 2920.32 and
. The peaks at 3448.68, 2920.32 and  were corresponding to the C=C stretching vibration of alkanes. The peak at
were corresponding to the C=C stretching vibration of alkanes. The peak at  signals the P-H phosphine sharp stretching of miscellaneous group. The peak at
signals the P-H phosphine sharp stretching of miscellaneous group. The peak at  corresponds to the C=O stretching of amides. The peak at
corresponds to the C=O stretching of amides. The peak at  represents the Ar C-C stretching vibration of Aromatics. Similarly, the peak at
represents the Ar C-C stretching vibration of Aromatics. Similarly, the peak at  could be responsible for the -CH3 stretching vibration of alkanes. The peak at
could be responsible for the -CH3 stretching vibration of alkanes. The peak at  signals the C-N stretching vibration of amines. The peak at
signals the C-N stretching vibration of amines. The peak at  shows the C-Br stretching of Alkyl halides. FTIR spectrum of SW-AgNPs (figure 5(b)) showed the presence of peaks at 3448.90, 2360.84, 2337.83, 2053.33, 1635.69, 1406.23, 1213.26, 1106.83, 1045.68 and
shows the C-Br stretching of Alkyl halides. FTIR spectrum of SW-AgNPs (figure 5(b)) showed the presence of peaks at 3448.90, 2360.84, 2337.83, 2053.33, 1635.69, 1406.23, 1213.26, 1106.83, 1045.68 and  . The peak at
. The peak at  could be assigned to the NH stretching vibration of amines. The peaks at 2360.84, 2337.83 and
could be assigned to the NH stretching vibration of amines. The peaks at 2360.84, 2337.83 and  signal the Si-H silane stretching vibrations of miscellaneous group. The peak at
signal the Si-H silane stretching vibrations of miscellaneous group. The peak at  signals the C=O stretching of amides. The peaks at 1406.23 and
signals the C=O stretching of amides. The peaks at 1406.23 and  were signals for the C-Br stretching of alkyl halides. The peak at
were signals for the C-Br stretching of alkyl halides. The peak at  was responsible for the C-O stretching vibration of carboxylic acids. The peaks at 1045.68 and
was responsible for the C-O stretching vibration of carboxylic acids. The peaks at 1045.68 and  could be assigned to the O-H stretching vibrations of alcohols (table 2). The plant/seaweed extracts contains functional groups such as amide, amine, alkane, alkene, carboxylic acids and methylene that are reported to be an important reducing agent for the synthesis of silver nanoparticles [34].
could be assigned to the O-H stretching vibrations of alcohols (table 2). The plant/seaweed extracts contains functional groups such as amide, amine, alkane, alkene, carboxylic acids and methylene that are reported to be an important reducing agent for the synthesis of silver nanoparticles [34].
Table 2. FTIR analysis of SW-AE and SW-AgNPs.
| Sample | Vibration  |
Stretch | Functional group |
|---|---|---|---|
| SW-AE | 3448.68 | C=C | Alkanes |
| 2920.32 | C=C | Alkanes | |
| 2852.88 | C=C | Alkanes | |
| 2360.77 | P-H phosphine sharp | Miscellaneous | |
| 1636.59 | C=O | Amides | |
| 1463.69 | Ar C-C | Aromatics | |
| 1383.79 | −CH3 | Alkanes | |
| 1109.73 | C-N | Amines | |
| 598.89 | C-Br | Alkyl halides | |
| SW-AgNPs | 3448.90 | NH | Amines |
| 2360.84 | Si-H silane | Miscellaneous | |
| 2337.83 | Si-H silane | Miscellaneous | |
| 2053.33 | Si-H silane | Miscellaneous | |
| 1635.69 | C=O | Amides | |
| 1406.23 | C-Br | Alkyl halides | |
| 1213.26 | C-Br | Alkyl halides | |
| 1106.83 | C-O | Carboxylic acids | |
| 1045.68 | O-H | Alcohols | |
| 602.74 | O-H | Alcohols | |
Figure 4. XRD analysis of SW-AgNPs.
Download figure:
Standard image High-resolution imageFigure 5. FTIR spectra of (a) SW-AE and (b) SW-AgNPs.
Download figure:
Standard image High-resolution imagePresently, the FTIR analysis of both SW-AE and SW-AgNPs revealed the presence of carboxylic acids, alkanes and amines that might be responsible for the capping of silver ions with the bioactive compounds of seaweed extract. The FESEM micrographic analysis of SW-AgNPs revealed the presence of irregular spherical shaped nanoparticles with the size range of  (figures 6(a) and (b)). The earlier research of Veerakumar et al [31] revealed the size range of the synthesized silver nanoparticles from aqueous leaf extract of Feronia elephantum, as 20–60 nm, which is in line with our present findings. The energy dispersive x-ray spectroscopy analysis of the synthesized silver nanoparticles strongly confirmed the presence of elemental silver as a major constituent in the SW-AgNPs (figure 6(c)). Magudapatty et al [35] have reported that the silver nanocrystals generally indicate a peak at 3 keV. Presently, the SW-AgNPs showed such peak confirming the presence of metallic silver in the nanoparticles. In addition to this, the Energy dispersive x-ray spectroscopy (EDX) pattern also shows the signal for O that might have originated from the aqueous extract of the S. wightii. The colloidal state of the synthesized nanoparticles have been confirmed through the zeta potential analysis SW-AgNPs shows the negative value at −15.2 mV (figure 7(a)). The negative zeta potential value of the SW-AgNPs reveals the long term stability of the nanoparticles. The particle size analysis exposed the
(figures 6(a) and (b)). The earlier research of Veerakumar et al [31] revealed the size range of the synthesized silver nanoparticles from aqueous leaf extract of Feronia elephantum, as 20–60 nm, which is in line with our present findings. The energy dispersive x-ray spectroscopy analysis of the synthesized silver nanoparticles strongly confirmed the presence of elemental silver as a major constituent in the SW-AgNPs (figure 6(c)). Magudapatty et al [35] have reported that the silver nanocrystals generally indicate a peak at 3 keV. Presently, the SW-AgNPs showed such peak confirming the presence of metallic silver in the nanoparticles. In addition to this, the Energy dispersive x-ray spectroscopy (EDX) pattern also shows the signal for O that might have originated from the aqueous extract of the S. wightii. The colloidal state of the synthesized nanoparticles have been confirmed through the zeta potential analysis SW-AgNPs shows the negative value at −15.2 mV (figure 7(a)). The negative zeta potential value of the SW-AgNPs reveals the long term stability of the nanoparticles. The particle size analysis exposed the  average of SW-AgNPs are 343.6 (d.nm) and Pdi is 0.607 (figure 7(b)).
average of SW-AgNPs are 343.6 (d.nm) and Pdi is 0.607 (figure 7(b)).
Figure 6. FESEM micrograph analysis of SW-AgNPs: (a) magnified at 50,000×, (b) magnified at 120,000×, and (c) EDX pattern of SW-AgNPs.
Download figure:
Standard image High-resolution imageFigure 7. (a) Zeta potential and (b) particle size distribution of SW-AgNPs.
Download figure:
Standard image High-resolution image3.4.  amylase inhibitory activity
amylase inhibitory activity
The complex carbohydrate molecules present in the diet is broken down into simple sugars like glucose due to the action of an enzyme alpha-amylase which is present in human saliva. Hence, the inhibition of  amylase could control the enzyme action, carbohydrate metabolism and which also decrease the amount of glucose absorption. Natural
amylase could control the enzyme action, carbohydrate metabolism and which also decrease the amount of glucose absorption. Natural  amylase inhibitors offer an attractive therapeutic approach in the treatment of postprandial hyperglycemia, with final reduced glucose release from starch. Seaweeds that can reduce postprandial hyperglycemia by inhibiting enzymes such as
amylase inhibitors offer an attractive therapeutic approach in the treatment of postprandial hyperglycemia, with final reduced glucose release from starch. Seaweeds that can reduce postprandial hyperglycemia by inhibiting enzymes such as  amylase and
amylase and  glucosidase are found to be an effective tool for the management of diabetes [36]. The recorded inhibitory percentages of
glucosidase are found to be an effective tool for the management of diabetes [36]. The recorded inhibitory percentages of  amylase by SW-AE and SW-AgNPs are shown in figure 8(a). In our study SW-AgNPs has showed the highest inhibitory percentage of
amylase by SW-AE and SW-AgNPs are shown in figure 8(a). In our study SW-AgNPs has showed the highest inhibitory percentage of  amylase when compared to the SW-AE with the
amylase when compared to the SW-AE with the  values
values  of
of  and
and  , respectively. The positive control acarbose has shown the potent α-amylase inhibitory activity with the
, respectively. The positive control acarbose has shown the potent α-amylase inhibitory activity with the  value
value  of
of  . Abideen et al [37] have reported that silver nanoparticles of Gracillaria edulis and Syringodium isoetifolium have shown α-amylase inhibition of 98.75% and 77.25%, respectively.
. Abideen et al [37] have reported that silver nanoparticles of Gracillaria edulis and Syringodium isoetifolium have shown α-amylase inhibition of 98.75% and 77.25%, respectively.
Figure 8. Enzyme inhibitory activities of SW-AE and SW-AgNPs: (a)  amylase inhibiton and (b)
amylase inhibiton and (b)  glucosidase inhibiton.
glucosidase inhibiton.
Download figure:
Standard image High-resolution image3.5.  glucosidase inhibitory activity
glucosidase inhibitory activity
The recorded rates of inhibition of SW-AE and SW-AgNPs on  glucosidase are depicted in figure 8(b). The maximum inhibition
glucosidase are depicted in figure 8(b). The maximum inhibition  glucosidase was exerted by SW-AgNPs followed by SW-AE with the
glucosidase was exerted by SW-AgNPs followed by SW-AE with the  values
values  of
of  and
and  , respectively. And the effective inhibition of
, respectively. And the effective inhibition of  glucosidase was recorded by the positive control, acarbose with the
glucosidase was recorded by the positive control, acarbose with the  value
value  of 31.75 ± 2.89. During the earlier study, Senthilkumar et al [38] have found that the Enhalus acoroides mediated AgNPs exhibited a strong inhibitory potential with an
of 31.75 ± 2.89. During the earlier study, Senthilkumar et al [38] have found that the Enhalus acoroides mediated AgNPs exhibited a strong inhibitory potential with an  value of
value of  , which is comparable to that of our present results.
, which is comparable to that of our present results.
3.6. DPPH radical scavenging assay
The DPPH scavenging property of SW-AE and SW-AgNPs was compared with the positive control, ascorbic acid (figure 9(a)). Among the different concentrations of samples/control used in this study, the  of SW-AgNPs resulted in the highest scavenging effect of 64.96% followed by SW-AE 30.35% and positive control, ascorbic acid showed 80.16% inhibition. The
of SW-AgNPs resulted in the highest scavenging effect of 64.96% followed by SW-AE 30.35% and positive control, ascorbic acid showed 80.16% inhibition. The  values
values  of SW-AE, SW-AgNPs and ascorbic acid were:
of SW-AE, SW-AgNPs and ascorbic acid were:  ,
,  and
and  , respectively. Natural antioxidants are not limited to terrestrial sources and some earlier investigations have revealed that seaweeds possess good number of natural antioxidant compounds. The presence of antioxidant substances in seaweeds are considered to be an endogenous defense mechanism, as a protection against oxidative stress due to extreme level of environmental conditions [39].
, respectively. Natural antioxidants are not limited to terrestrial sources and some earlier investigations have revealed that seaweeds possess good number of natural antioxidant compounds. The presence of antioxidant substances in seaweeds are considered to be an endogenous defense mechanism, as a protection against oxidative stress due to extreme level of environmental conditions [39].
Figure 9. Antioxidant activities of SW-AE and SW-AgNPs (a) DPPH inhibition and (b) FRAP inhibition.
Download figure:
Standard image High-resolution image3.7. Ferric ion reducing power (FRAP) assay
Among the various concentrations tested, only the  of SW-AgNPs resulted in the highest scavenging effect of 58.73% followed by SW-AE with the lowest inhibition of 22.53%. And the positive control, ascorbic acid showed 61.21% (figure 9(b)). The recorded
of SW-AgNPs resulted in the highest scavenging effect of 58.73% followed by SW-AE with the lowest inhibition of 22.53%. And the positive control, ascorbic acid showed 61.21% (figure 9(b)). The recorded  values
values  of SW-AE, SW-AgNPs and ascorbic acid were:
of SW-AE, SW-AgNPs and ascorbic acid were:  ,
,  and
and  , respectively. Some earlier research revealed that the synergistic effect of Ecklonia cava extract and biosynthesized AgNPs resulted in highest antioxidant activity [40]. Interestingly in our study, the synergistic effect of the biosynthesized silver nanoparticles from S. wightii showed increased antioxidant effects and hence its AgNPs could form a good candidate as pharmaceutical and nutraceutical product.
, respectively. Some earlier research revealed that the synergistic effect of Ecklonia cava extract and biosynthesized AgNPs resulted in highest antioxidant activity [40]. Interestingly in our study, the synergistic effect of the biosynthesized silver nanoparticles from S. wightii showed increased antioxidant effects and hence its AgNPs could form a good candidate as pharmaceutical and nutraceutical product.
3.8. Antibacterial activity
Some earlier investigations found that the antibacterial activity of silver nanoparticles is much efficient than the silver ions [41]. Our present study also revealed that the synthesized silver nanoparticles from aqueous seaweed extract of S. wightii have showed maximum bactericidal activity than the silver ions (figures 10 and 11). The maximal antibacterial activity of SW-AgNPs was recorded against E. coli, followed by S. flexneri, S. typhimurium, B. cereus, B. subtilis and E. faecalis. No activity was found against Pseudomonas aeruginosa. Recent research showed that the silver nanoparticles fabricated from leaf extracts of Eriobotrya japonica and endophytic fungi, Penicillium spp. have exerted maximal antibacterial activity against E. coli, P. aeruginosa and Staphylococcus aureus [42, 43]. The antibacterial activity of plant/seaweed mediated synthesized silver nanoparticles was shown to be more effective bactericidal agent than the chemical synthesized nanoparticles [44]. Presently, SW-AgNPs have shown maximal antibacterial activity only on gram negative bacteria followed by gram positive bacteria. Erjaee et al [45] have reported that the silver nanoparticles are more sensitive to gram negative bacteria whereas less sensitive to gram positive bacteria due to the presence of wider cellular wall that contains multiple layers of peptidoglycan which might be the reason for the recorded bactericidal effect of SW-AgNPs. The reduced size of silver nanoparticles with the 20–80 nm size-ranges can instantly interact with bacterial cell wall and release silver ions which could penetrate into the bacterial cell and attach to the thiol groups of proteins and they prevent the DNA replication, resulting in bacterial inactivation [46]. The antibacterial property of synergistic nano-composites revealed the enhanced bactericidal activity. Recently, the antibacterial activity of silver and silver chloride in combination with nanoparticles of Solidago altissima-leaf extract has shown effective bactericidal activity at minimal concentration of  [47].
[47].
Figure 10. Antibacterial activity of SW-AE and SW-AgNPs against (a) E. coli, (b) S. flexneri, (c) S. typhimurium, (d) B. cereus, (e) B. subtilis and (f) E. faecalis.
Download figure:
Standard image High-resolution imageFigure 11. A bar graph showing antibacterial potential of SW-AgNPs against various bacterial pathogens.
Download figure:
Standard image High-resolution image4. Conclusion
Green synthesis of silver nanoparticles from the seaweed S. wightii is a simple, low cost and eco-friendly method and the AgNPs exerted good enzyme inhibitory, antibacterial and antioxidant effects. Further, the reduced size of silver nanoparticles of brown alga might be the reason for the recorded inhibitory activity. Hence, the research findings obtained in the present work might be of important baseline data for further studies towards the initiation of new novel pharmaceutical/drug formulation for treating diabetes mellitus.
Acknowledgments
We are grateful to the authorities of the Periyar University for providing the necessary facilities to carry out this research work. The first author is grateful to the authorities of the Periyar University for the grant of University Research Fellowship (Lr. No. PU/AD3/URF/2017).